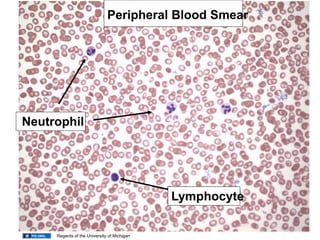
Peripheral Blood Smear
Neutrophil
Lymphocyte
Regents of the University of Michigan
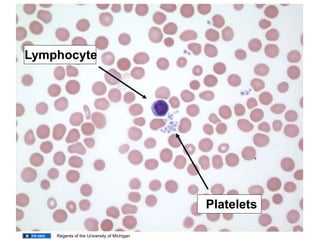
Lymphocyte
Platelets
Regents of the University of Michigan
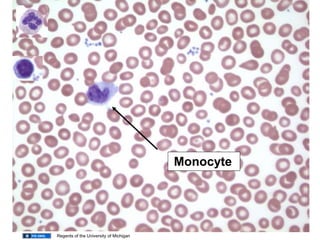
Monocyte
Regents of the University of Michigan

1. The document discusses inflammation and the cellular responses involved. It describes the multiple causes of inflammation and outlines the classic five signs of inflammation: heat, redness, swelling, pain, and loss of function.
2. The summary of the inflammatory process involves four key steps: 1) vasodilation and increased blood flow, 2) increased vascular permeability, 3) leukocyte exudation into tissues, and 4) phagocytosis and killing of pathogens by cells such as neutrophils.
3. Chemical mediators released during inflammation, such as histamine, prostaglandins, and cytokines, help regulate the inflammatory response both locally and systemically.

![Immunogens and antigens
• Immunogen / antigen: a substance that elicits
an immune response [i.e. a humoral (antibody
response) or cell-mediated immune response]
Immune response generator
Though the two terms are used interchangeably – there are differences between
the two
Antigen: any substance that binds to an antibody (or a T-cell
receptor) – But some antigens cannot elicit an immune
response.
All immunogens are antigens but not all antigens are
immunogens](https://image.slidesharecdn.com/lect-3-inflammation-210605132336/85/Lect-3-inflammation-64-320.jpg)


















